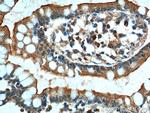
GPR128 Antibody in Immunohistochemistry (Paraffin) (IHC (P))
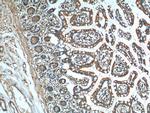
GPR128 Antibody in Immunohistochemistry (Paraffin) (IHC (P))

Search
Proteintech
GPR128 Polyclonal Antibody
{{$productOrderCtrl.translations['antibody.pdp.commerceCard.promotion.promotions']}}
{{$productOrderCtrl.translations['antibody.pdp.commerceCard.promotion.viewpromo']}}
{{$productOrderCtrl.translations['antibody.pdp.commerceCard.promotion.promocode']}}: {{promo.promoCode}} {{promo.promoTitle}} {{promo.promoDescription}}. {{$productOrderCtrl.translations['antibody.pdp.commerceCard.promotion.learnmore']}}
产品信息
24784-1-AP
种属反应
宿主/亚型
分类
类型
抗原
偶联物
形式
浓度
规格
纯化类型
保存液
内含物
保存条件
运输条件
产品详细信息
Immunogen sequence: GIWRIVIRI QRGKSTSSSS TPTEFCRNGG TWENGRCICT EEWKGLRCTI ANFCENSTYM GFTFARIPVG RYGPSLQTCG KDTPNAGNPM AVRLCSLSLY GEIELQKVTI GNCNENLETL EKQVKDVTAP LNNISSEVQI LTSDANKLTA ENITSATRVV GQIFNTSRNA SPEAKKVAIV TVSQLLDASE DAFQRVAATA NDDALTTLIE QMETYSLSLG NQSVVEPNIA IQSANFSSEN AVGPSNVRFS VQKGASSSLV SSSTFIHTNV DGLNPDAQTE LQVLLNMTKN YTKTCGFVVY QNDKLFQSKT FTAKSDFSQK IISSKTDENE QDQSASVDMV FSPKYNQKEF QLYSYAC (28-383 aa encoded by BC113451)
靶标信息
GPRs are characterized by the presence of 7 transmembrane domains. GPR128 is an orphan receptor.
仅用于科研。不用于诊断过程。未经明确授权不得转售。
篇参考文献 (0)
生物信息学
蛋白别名: Adhesion G-protein coupled receptor G7; FLJ14454; FLJ16382; FLJ29035; G-protein coupled receptor 128; MGC142011; MGC163260; unnamed protein product
基因别名: ADGRG7; GPR128
UniProt ID: (Human) Q96K78
Entrez Gene ID: (Human) 84873